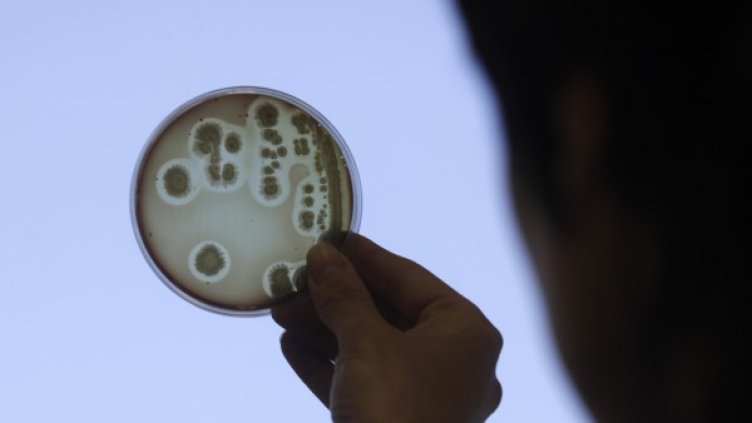
Снимка: Reuters, архив

Срещу този вирус (А 71 - бел.ред.) няма ваксина и няма специфично лечение, обяви д-р Атанас Мангъров, началник на Детската клиника по инфекциозни болести към Инфекциозна болница в София, в Сутрешния блок на Bulgaria ON AIR по повод ентеровирусът А 71, който се разпространява в Испания.
Той припомни, че ентеровирусът е свързан с България в миналото, защото пред 1975 г. предизвиква най-голямата епидемия в страната. За ситуацията в Испания докторът коментира, че заболяването не е често, но когато се появи може да причини сериозни проблеми.
По думите му ентеровирусите са заболявания, които причиняват т.нар. "летни грипове".
"Грипоподобните заболявания, които са най-често през топлите месеци, протичат с температура, повръщане, болки в гърлото, обриви, обезводняване и с не много силна диария", посочи той.
Медикът обясни, че е възможно заболяванията да засегнат нервната система и се получава минингит, който е като "хрема на мозъка".
"Когато нещата тръгнат накриво може да се засегне мозъчното вещество, при което, когато се засегнат центровете на дишането и сърдечната дейност, може да се стигне до смъртен изход", посочи д-р Мангъров.
От разговора стана ясно, че вирусът няма ясни показатели, различни от тези на едно банално грипоподобно разболяване. Докторът посочи, че е възможно да се стигне до крайна парализа, но парализите са обратими. "Когато се засегнат центровете на дишането и сърдечната дейност, тогава е опасно", обясни гостът.
"Няма специфично лечение - то е чисто симптоматично и генетично", категоричен е специалистът. Според него прогнозите за болестта в Испания, са благоприятни, но е и въпрос на късмет.
"Шансът вирусът да дойде у нас е малък", уточни д-р Мангъров. Той обясни, че превенцията е добра лична хигиена и избягване на контакти с други болни. "Опасност реална няма, теоретична има", каза той.
По думите му най-засегнати са активните деца до 10 г., а разпространението му става чрез фекално замърсяване и по въздушно-капков път.
Това се случи Dnes, за важното през деня ни последвайте и в Google News Showcase.

Петролът поскъпва, разговорите между Иран и САЩ остават във фокуса на инвеститорите*
Петролът поскъпва, разговорите между Иран и САЩ остават във фокуса на инвеститорите*  САЩ чакат Русия да вземе Донбас и преговорите за мир да продължат
САЩ чакат Русия да вземе Донбас и преговорите за мир да продължат  Куба има малко варианти за отговор при военен натиск от САЩ
Куба има малко варианти за отговор при военен натиск от САЩ  Гръцките акции срещу Nasdaq 100: Кой пазар се представи по-добре през последните 5 години?
Гръцките акции срещу Nasdaq 100: Кой пазар се представи по-добре през последните 5 години?  Съобщение за проект на мирно споразумение между САЩ и Иран обнадежди пазарите
Съобщение за проект на мирно споразумение между САЩ и Иран обнадежди пазарите  След посещението на Путин в Пекин Русия ще пласира облигации, деноминирани в юани
След посещението на Путин в Пекин Русия ще пласира облигации, деноминирани в юани 
 Автомобилите с ръчни скорости изчезват до 2030 г.?
Автомобилите с ръчни скорости изчезват до 2030 г.?  В "България сутрин" на 23 май от 09:30 часа: Опасни ли са хранителните добавки?
В "България сутрин" на 23 май от 09:30 часа: Опасни ли са хранителните добавки?  Рецепта за италианско предястие с пушена сьомга
Рецепта за италианско предястие с пушена сьомга  САЩ започват военни учения над Венецуела
САЩ започват военни учения над Венецуела  Обявяват първото класиране за прием в детските градини и ясли в София
Обявяват първото класиране за прием в детските градини и ясли в София  3 зодии привличат финансов успех между 25 и 31 май 2026 г. – съдбата им носи големи пари
3 зодии привличат финансов успех между 25 и 31 май 2026 г. – съдбата им носи големи пари 
 Вратарят на Монтана потегли за Мондиал 2026
Вратарят на Монтана потегли за Мондиал 2026  Локо София с резервите срещу Спартак Варна
Локо София с резервите срещу Спартак Варна  Рико Верхувен с рекорден хонорар за мегабитката срещу Усик + ВИДЕО
Рико Верхувен с рекорден хонорар за мегабитката срещу Усик + ВИДЕО  Христо Янев награди ЦСКА
Христо Янев награди ЦСКА  Огромни суперлативи за новия герой на ЦСКА
Огромни суперлативи за новия герой на ЦСКА  Голям трансфер: Левски продава звездата си в Англия?
Голям трансфер: Левски продава звездата си в Англия? 
 Как да остарявате с гордост без антиейдж обсесия
Как да остарявате с гордост без антиейдж обсесия  Кекс с череши и рикота за Черешова задушница
Кекс с череши и рикота за Черешова задушница  Гергана Филипова и Мирослав Тънгаров спечелиха двата кастинга на Театър„ София“!
Гергана Филипова и Мирослав Тънгаров спечелиха двата кастинга на Театър„ София“!  Женски хороскоп за юни 2026
Женски хороскоп за юни 2026  „Опасно близо“, петата книга от поредицата за една от най-харесваните детективки в жанра – Трейси Кросуайт
„Опасно близо“, петата книга от поредицата за една от най-харесваните детективки в жанра – Трейси Кросуайт  Нумерологична прогноза за 22 май
Нумерологична прогноза за 22 май 
 продава, Двустаен апартамент, 67 m2 София, Надежда 2, 150000 EUR
продава, Двустаен апартамент, 67 m2 София, Надежда 2, 150000 EUR  продава, Четиристаен апартамент, 132 m2 София, Витоша, 310220 EUR
продава, Четиристаен апартамент, 132 m2 София, Витоша, 310220 EUR  продава, Парцел, 4335 m2 Бургас област, гр.Поморие, 219000 EUR
продава, Парцел, 4335 m2 Бургас област, гр.Поморие, 219000 EUR  продава, Парцел, 1511 m2 Бургас област, с.Горица, 8000 EUR
продава, Парцел, 1511 m2 Бургас област, с.Горица, 8000 EUR  продава, Едностаен апартамент, 35 m2 Бургас област, с.Равда, 44278 EUR
продава, Едностаен апартамент, 35 m2 Бургас област, с.Равда, 44278 EUR  продава, Парцел, 467 m2 Стара Загора област, с.Преславен, 17000 EUR
продава, Парцел, 467 m2 Стара Загора област, с.Преславен, 17000 EUR 
 Виц на деня - 22 май
Виц на деня - 22 май  Хороскоп за 23 май 2026
Хороскоп за 23 май 2026  Мачовете по ТВ днес (22 май)
Мачовете по ТВ днес (22 май)  Битката за спасение в Първа лига се решава днес
Битката за спасение в Първа лига се решава днес  Без ток във Варна на 22 май 2026
Без ток във Варна на 22 май 2026  Времето във Варна на 22 май 2026
Времето във Варна на 22 май 2026 
 Отслабването на океанските течения може да удари Европа
Отслабването на океанските течения може да удари Европа  НАСА обяви програмата си за постоянна база на Луната – над 80 изстрелвания и кацания
НАСА обяви програмата си за постоянна база на Луната – над 80 изстрелвания и кацания  Китайски учени осъществиха безжично предаване на енергия
Китайски учени осъществиха безжично предаване на енергия  Слънцето изхвърли енергия към Меркурий: Ще достигне ли бурята до Земята?
Слънцето изхвърли енергия към Меркурий: Ще достигне ли бурята до Земята?  SpaceX е готова за Уолстрийт: Състоянието на Мъск може да скочи до 1 трилион долара
SpaceX е готова за Уолстрийт: Състоянието на Мъск може да скочи до 1 трилион долара  Откриха огромни залежи на литий в Апалачите: Стигат за 500 млрд. смартфона
Откриха огромни залежи на литий в Апалачите: Стигат за 500 млрд. смартфона 











